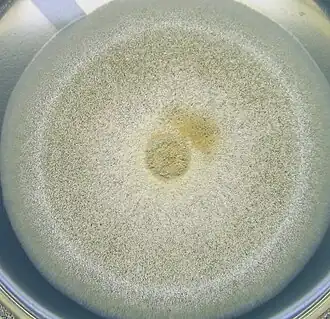

Аспергилл гнездовой
| Аспергилл гнездовой | ||||||||||
|---|---|---|---|---|---|---|---|---|---|---|
| ||||||||||
| Научная классификация | ||||||||||
|
Домен: Царство: Подцарство: Отдел: Подотдел: Класс: Подкласс: Eurotiomycetidae Порядок: Семейство: Aspergillaceae Род: Секция: Nidulantes Вид: Аспергилл гнездовой |
||||||||||
| Международное научное название | ||||||||||
| Aspergillus nidulans (Eidam) G.Winter, 1884 | ||||||||||
| ||||||||||
Асперги́лл гнездово́й (лат. Aspergíllus nídulans) — вид грибов-аскомицетов, относящийся к роду аспергилл (Aspergillus). Ранее это название относилось только к анаморфной стадии гриба, а телеоморфа именовалась эмерице́лла погружённая (Emericella nidulans).
Описание
Колонии на агаре Чапека с дрожжевым экстрактом (CYA) 4—5 см в диаметре на 7-е сутки, бархатистые, реже шерстистые, с белым мицелием и различной интенсивности конидиальным спороношением в зеленоватых тонах. Иногда выделяется фиолетовый растворимый пигмент. Реверс оранжевый, коричневый, фиолетово-коричневый, реже бледный. Обильны белые клейстотеции, окружённые белыми до желтоватых покровными клетками. При 37 °C колонии 5—7 см в диаметре, без воздушного мицелия, с более выраженным преобладанием аскоспорового спороношения. На агаре с солодовым экстрактом (MEA) колонии 3,5—6 см в диаметре на 7-е сутки, бархатистые или шерстистые, с преобладанием конидиального либо аскоспорового спороношения. Реверс бледный до фиолетово-коричневого.
Клейстотеции обильные, белые, затем тёмно-красные или светло-винные, 100—250 мкм в диаметре. Аскоспоры пурпурно-красные, эллипсоидальные, с двумя сближенными экваториальными гребнями, 3,8—6 мкм длиной.
Конидиеносные головки двухъярусные, с коричневой ножкой 60—150 мкм длиной, с полушаровидным апикальным вздутием до 8—12 мкм. Метулы покрывающие верхнюю половину или меньшую часть вздутия, 5—8 мкм длиной. Фиалиды 5—8 мкм длиной. Конидии шаровидные, шероховатые, 3—3,5 мкм в диаметре.
Отличия от близких видов
Определяется по быстрому росту при 37 °C, обильному образованию клейстотециев с покровными клетками, зеленоватому конидиальному спороношению, представленному двухъярусными головками на коричневых ножках.
Экология
Широко распространённый вид, часто выделяемый из почвы и с различных растительных субстратов. На пищевых продуктах встречается редко, наиболее часто — на зерне и зерновых продуктах.
Продуцент стеригматоцистина и сильнодействующего токсина эместрина.
Таксономия
Aspergillus nidulans (Eidam) G.Winter, Rabenh. Krypt.-Fl. ed. 2 1 (2): 62 (1884). — Sterigmatocystis nidulans Eidam, Beitr. Biol. Pflanzen 3: 392 (1883).
Синонимы
- Aspergillus nidulellus Samson & W.Gams, 1986, nom. superfl.
- Diplostephanus nidulans (Eidam) Neveu-Lem., 1921
- Emericella nidulans (Eidam) Vuill., 1927
- Sterigmatocystis nidulans Eidam, 1883
Литература
- Pitt J. I., Hocking A. D. Fungi and Food Spoilage. — Springer, 2009. — P. 279—281. — ISBN 978-0-387-92206-5. — doi:10.1007/978-0-387-92207-2.
- Пидопличко Н. М. Грибы-паразиты культурных растений. — Киев: Наукова думка, 1977. — Т. 2. — С. 50.